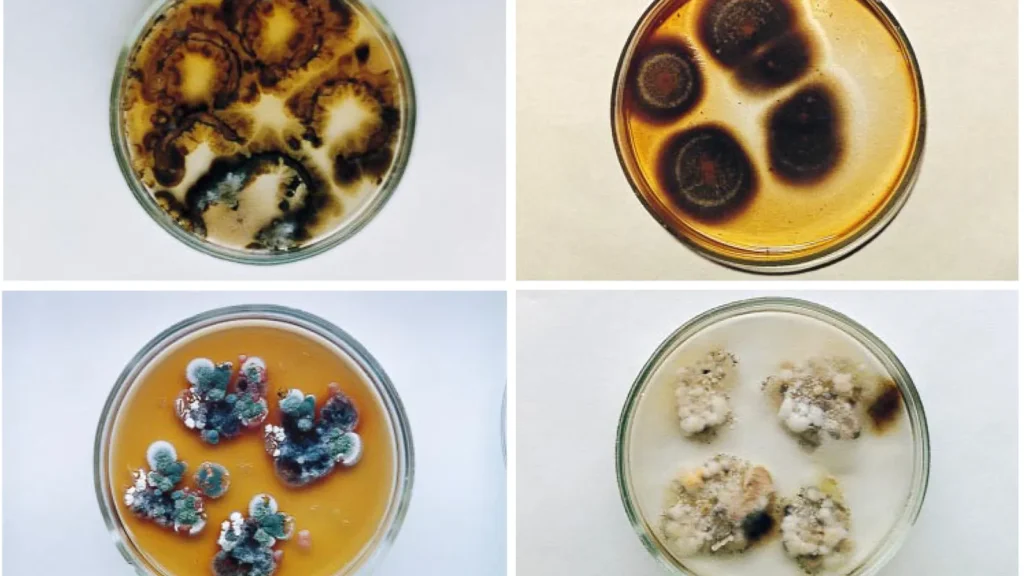

En 1997, Nelli Zhdanova est entrée dans l’un des lieux les plus radioactifs au monde : les ruines de la centrale nucléaire de Tchernobyl.
Sur les murs, les plafonds et dans les conduits métalliques, elle a découvert une vie inattendue : des moisissures noires prospéraient là où l’homme avait fui.
Ce n’était pas un hasard. Ces champignons semblaient attirés par les radiations ionisantes, défiant tout ce que l’on croyait savoir sur la vie dans des environnements extrêmes.
Une nature qui s’adapte au pire
À l’image des plantes qui se tournent vers la lumière, ces moisissures poussaient vers les sources de contamination.
Dans la « zone d’aliénation » de 30 km autour du réacteur numéro quatre, où les radiations restent dangereusement élevées depuis l’explosion de 1986, la vie animale et végétale renaissait progressivement.
Loups, sangliers, grenouilles et champignons ont trouvé des stratégies pour survivre là où les humains ne pouvaient pas.
La clé de cette résistance ? La mélanine, le pigment noir qui colore leurs parois cellulaires. Comme notre peau foncée protège des UV, la mélanine absorbe l’énergie des radiations et agit comme un bouclier naturel.
Radiosynthèse : se nourrir des radiations
Des études menées ensuite par Ekaterina Dadachova ont révélé que ces champignons ne se contentaient pas de survivre : ils semblaient utiliser l’énergie radioactive pour croître plus vite.
Ce phénomène, nommé « radiosynthèse », pourrait permettre à certains champignons de transformer des radiations potentiellement mortelles en source d’énergie pour leur métabolisme.
Cependant, seules certaines espèces montrent ce comportement : sur 47 espèces de champignons mélanisés collectées à Tchernobyl, seulement neuf poussaient activement vers les radiations.
Des expériences récentes dans l’espace confirment que la croissance peut être stimulée, mais la gravité et d’autres facteurs restent à isoler.
Des champignons à la Station spatiale
En 2018, la souche Cladosporium sphaerospermum, retrouvée à Tchernobyl, a été envoyée à la Station spatiale internationale.

Les résultats ont surpris les chercheurs : les champignons ont non seulement continué à croître, mais leur simple présence a réduit l’exposition aux radiations pour les capteurs placés en dessous.
Ces découvertes ouvrent des perspectives fascinantes pour l’exploration spatiale. Alors que les futures missions vers la Lune et Mars se préparent, les matériaux traditionnels comme le métal, le verre ou l’eau restent lourds et coûteux à transporter.
Une solution vivante, cultivée sur place, pourrait offrir une protection auto-régénératrice contre le rayonnement cosmique.
Une myco-architecture pour l’espace
Les chercheurs envisagent déjà des structures faites de champignons pour habiter les futurs avant-postes lunaires ou martiens.
Des murs et des meubles à base de mycélium pourraient former des boucliers naturels et réduire drastiquement les besoins en matériaux lourds.
Cette capacité des champignons à coloniser un environnement extrême sur Terre pourrait donc un jour aider l’homme à s’installer sur d’autres planètes, en transformant un danger invisible en une ressource vitale.
L’avenir entre science et imagination
Si la radiosynthèse reste encore partiellement théorique, le potentiel de ces champignons est réel.
Ils illustrent comment la vie peut se réinventer face aux pires menaces et offrent un modèle pour concevoir des protections durables dans l’espace.
De Tchernobyl à Mars, l’idée d’utiliser la nature comme alliée contre le rayonnement pourrait bien devenir l’une des clés de notre survie interstellaire.




Leave a reply
Vous devez vous connecter pour publier un commentaire.